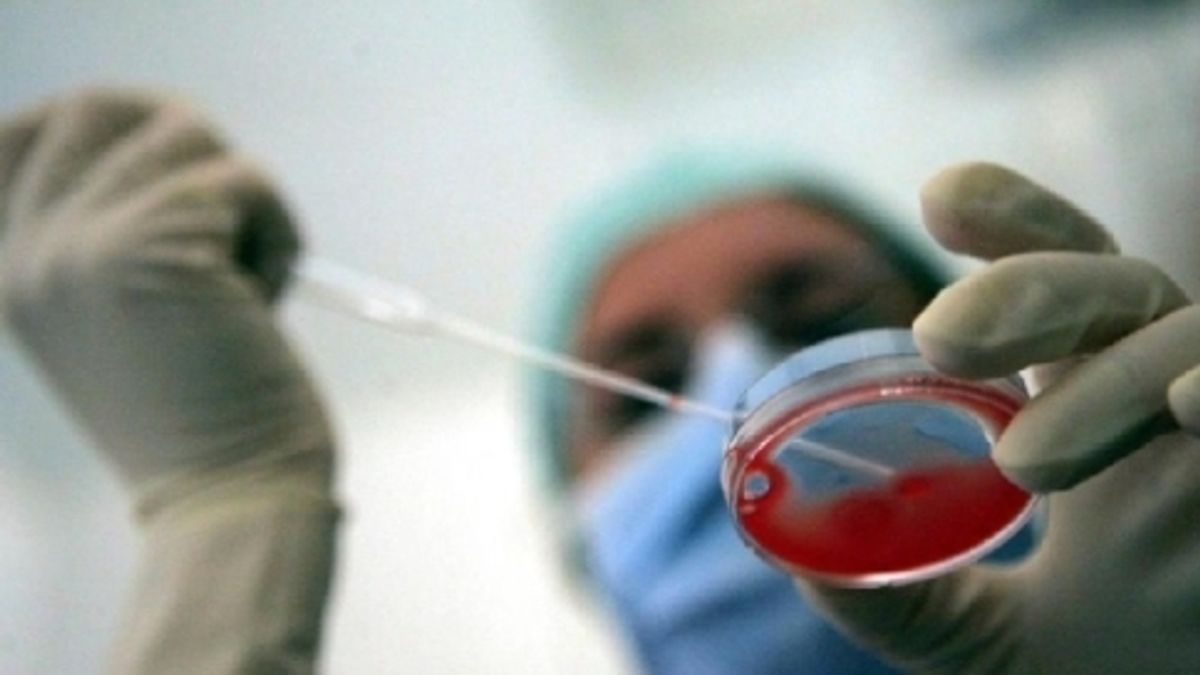

Terapie personalizzate per il tumore dei bambini grazie alla carta d'identità molecolare di ogni piccolo paziente. Un atto da compiere al momento della diagnosi e destinato ai piccoli malati che non rispondono a cure convenzionali o si ammalano di nuovo. Questo il progetto messo in piedi al reparto di Oncologia pediatrica dell'Umberto I di Roma per tentare, sfruttando terapie innovative e selettive, di curare anche i bimbi che non guariscono con cure convenzionali, circa uno su 4 dei piccoli a cui è diagnosticato un cancro.
Nuovi farmaci - Il pediatra Carlo Dominici spiega: "L'obiettivo è dare nuove chance di cura ai bambini che oggi ancora non riusciamo a salvare, attingendo a farmaci intelligenti e selettivi da poco disponibili e finora impiegati solo su pazienti adulti".
Intanto si stanno scoprendo nuovi bersagli terapeutici da colpire per guarire i bambini più sfortunati. Dominici ha appena pubblicato su Bmc Cancer la notizia di una molecola che normalmente sopprime la crescita di uno dei tumori solidi più frequenti nei bambini, il rabdomioblastoma. Si chiama miR-378 e la speranza è che riattivandola nei piccoli pazienti si possa bloccare la crescita del tumore.
Ogni paziente ha bisogno di un diverso approccio - I tumori sono tutti diversi e a ciascun paziente, spiega Dominici, corrisponde un diverso identikit molecolare della malattia: "L'idea è che se noi determiniamo (partendo da una biopsia) tale identikit subito all'ingresso del bimbo in ospedale, potremo in una certa misura capire in anticipo se il tumore risponderà alle terapie convenzionali e, soprattutto, saremo in grado di individuare tempestivamente nuove possibilità di cura per quei bimbi che ancora non riescono a guarire".
L'esperto spiega: "Da gennaio vogliamo iniziare a studiare sistematicamente l'identikit molecolare in ogni bimbo che arrivi in reparto. Sarà possibile realizzare questo sogno anche grazie al contributo dell'associazione "Io, domani" che aiuta il reparto sin dalla sua fondazione".